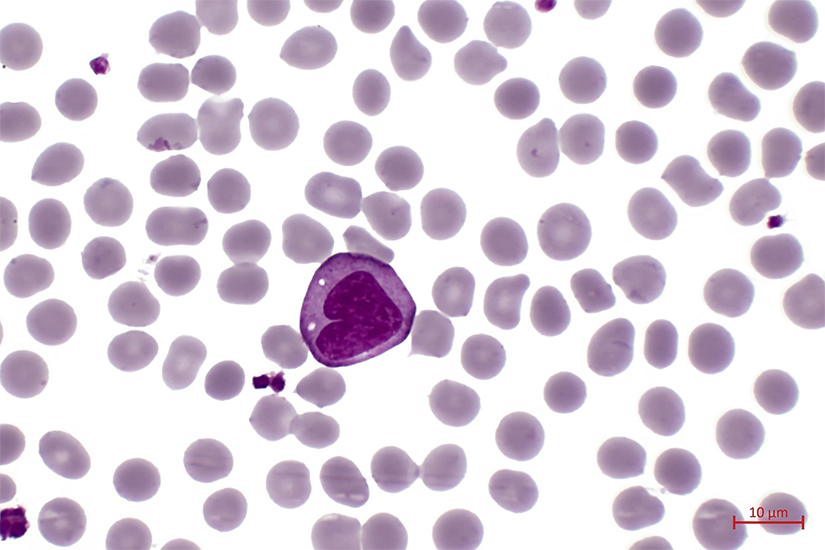

Contactează-ne!
Ai simptome care te supără? Solicită chiar acum un sfat medical specializat.

Monocitoza inseamna o crestere a numarului de monocite care circula in sange. Monocitele sunt un tip de celule albe sanguine (leucocite) si sunt produse in maduva osoasa. Monocitele reprezinta aproximativ 0-10% (0-1000/microL sange) din leucocitele circulante. Monocitele au un rol crucial in raspunsul imun al organismului.
Monocitele sunt cele mai mari leucocite din sange si dupa cateva ore in fluxul sanguin migreaza in tesuturi unde se diferentiaza in macrofage. Monocitele si macrofagele sunt componente cheie ale sistemului fagocitic mononuclear care este parte din sistemul imunitar. Aceste celule indeplinesc o varietate larga de functii importante in organism, fiind implicate in indepartarea microorganismelor, a particulelor straine si celulelor imbatranite, moarte sau alterate. De asemenea, servesc ca celule prezentatoare de antigen si regleaza raspunsul imun si inflamatia prin interactiunea cu limfocitele, un tip de leucocite care includ limfocitele T, limfocitele B si limfocitele NK (natural killer).
Numarul normal de monocite din sange este cuprins intre 0-1000 per microlitru si este determinat in cadrul hemoleucogramei, o analiza uzuala de sange. Organizatia Mondiala a Sanatatii (OMS) defineste monocitoza ca un numar absolut de monocite >1000 per microlitru de sange si > 10% din leucocite.
Monocitoza este un semn al unei alte afectiuni sau conditii medicale subiacente. Este frecvent intalnita in clinica si necesita investigatii adecvate datorita unei game largi de diagnostice diferentiale. De exemplu, monocitoza este adesea un marker al inflamatiei care apare ca urmare a unei infectii (virale, bacteriene sau parazitare). Un numar crescut de monocite poate sa apara in anumite boli autoimune si cancere de sange sau mai rar, in cadrul unor tezaurismoze (boli genetice rare in care se acumuleaza lipide complexe). Anumite medicamente sau radioterapia pot, de asemenea, cauza monocitoza. In plus, evenimente stresante pentru organism, cum ar fi un infarct miocardic acut, operatia de indepartare a splinei (splenectomia) sau o activitate fizica extenuanta pot determina cresterea temporara a numarului de monocite. Odata stabilit diagnosticul, tratamentul este cel al bolii de baza.
Ce sunt monocitele?
Monocitele sunt un tip de leucocite (celule albe sanguine). Sunt cel mai mare tip de leucocite din sange si sunt produse in maduva hematogena din celulele precursoare denumite monoblasti care la randul lor se diferentiaza din celulele stem hematopoietice (celule capabile sa se transforme in orice tip de celula functionala a sangelui si a sistemului imunitar).
Monocitele circula de obicei in fluxul sanguin timp de 1-3 zile inainte de a patrunde in tesuturi si de a se maturiza in macrofage sau celule dendritice.

Ce functii au monocitele?
Pentru a-si exercita functiile, monocitele au proprietatea de a migra din sange in diverse tesuturi (cum ar fi splina, ficatul, plamanii si ganglionii limfatici) unde exista un aflux important de antigene. Antigenele sunt substante din corp sau din exterior care nu sunt recunoscute ca proprii organismului si care determina aparitia unui raspuns imun, care vizeaza neutralizarea si eliminarea lor.
In tesuturi, moncitele se diferentiaza in macrofage care raman o perioada de cateva luni. Monocitele si macrofagele sunt componente cheie ale sistemului fagocitic mononuclear implicat in ingerarea si distrugerea de microorganisme si materiale straine in diferite tesuturi. Monocitele sunt responsabile pentru reglarea raspunsurilor inflamatorii si imune prin interactiunea cu alte celule albe din sange si servesc ca celule care pot procesa antigenele prin diferentierea in celule dendritice (responsabile pentru initierea raspunsului imun adaptativ).
Principalele 3 functii in sistemul imun ale monocitelor si macrofagelor sunt:

Fagocitoza
- Fagocitoza provine din cuvantele grecesti phagein care inseamna „a manca” si kytos, celula
- Este un proces de aparare impotriva infectiilor si agresiunilor prin care microbii si alte particule sunt ingurcitate (inglobate) in celula monocitului sau a macrofagului. Materialul ingerat este apoi digerat si distrus.
- Bacteriile, celulele imbatranite sau moarte ale tesuturilor, celulele canceroase, particulele minerale mici si substantele straine care nu au pe suprafata lor proteine specifice celulelor sanatoase ale corpului sunt toate exemple de materiale care pot fi fagocitate.
- Fagocitoza este unul dintre mecanismele principale ale apararii imunitare innascute, fiind unul dintre primele procese care raspund la infectie si, de asemenea, una dintre ramurile initiale ale raspunsului imun adaptativ.
- Fagocitoza este un proces de aparare vechi din punct de vedere evolutiv, fiind prezenta chiar si la animalele nevertebrate, nici un animal neputand trai fara acest tip de aparare.
Prezentarea de antigene si activarea limfocitelor T
- Prezentarea de antigene este un proces in care fragmentele microbiene sau de particule straine care sunt prezente in monocite sau macrofage dupa fagocitoza sunt incorporate in molecule specifice care detin un rol important in procesul de recunoastere a structurilor self (proprii organismului) vs. structurilor non-sef (straine organismului).
- Aceste particule sunt apoi transportate pe suprafata celulara a monocitului sau macrofagului si prezentate ca antigene pentru a activa limfocitele T, care produc un raspuns imun specific impotriva antigenului respectiv.
Productia de citokine
Monocitele si macrofagele au, de asemenea, un rol pro-inflamator si anti-inflamator prin eliberarea unor cantitati mari de citokine. Citokinele sunt esentiale pentru combaterea infectiilor si in alte raspunsuri imune.
Care este numarul normal de monocite?
Medicul de familie poate constata numarul de monocite cand efectuezi un test de sange de rutina denumit hemoleucograma. Hemoleucograma este efectuata in mod obisnuit in cadrul analizelor controlului medical periodic.
Numarul absolut normal de monocite din sange este cuprins intre 0-1000/microL sau 0-1×109/L. Monocitele reprezenta 0-10% din numarul total de leucocite.
Ce este monocitoza?
Organizatia Mondiala a Sanatatii (OMS) defineste monocitoza (numar crescut de monocite) ca un numar absolut de monocite >1000/microL de sange si un procent de monocite > 10% din leucocite.
Urmatoarele conditii medicale pot creste numarul de monocite:
- Infectii virale
- Infectii bacteriene
- Infectii parazitice
- Afectiuni autoimune
- Boli cronice inflamatorii
- Cancere
- Medicamente
- Evenimente stresante acute pentru organism
Ce afectiuni sau conditii medicale determina monocitoza?
Un numar mare de monocite este un semn potential al multor afectiuni sau conditii medicale diferite. Monocitoza poate semnifica o afectiune medicala severa, cum ar fi o boala autoimuna, un cancer de sange sau o boala cardiovasculara (infarct miocardic acut). De asemenea, poate insemna ca ai o infectie virala, bacteriana sau cu paraziti. In plus, poate indica un stres crescut sau recuperarea dupa o boala.
Monocitoza tranzienta
- Monocitoza poate fi observata la un pacient la care maduva osoasa este in curs de recuperare dupa chimioterapie citotoxica si reprezinta un semn favorabil.
- Evenimente stresante, cum ar fi operatia de splenectomie (de indepartare a splinei), infarctul miocardic acut si exercitiile fizice intense pot, de asemenea, determina cresterea numarului de monocite, care este adesea tranzitorie si reversibila.
- De asemenea, monocitoza este o aparitie frecventa la pacientii cu boala acuta, cu infectii sau boli respiratorii. Anumite infectii bacteriene acute, cum ar fi leptospiroza sau listerioza, pot fi asociate in mod clasic cu monocitoza. Recent, boala COVID-19 cauzata de infectia cu SARS-CoV-2 a fost asociata cu cresterea anumitor monocite inflamatorii in cazurile usoare si a monocitelor disfunctionale in cazurile severe, evidentiind rolul important al monocitelor in reglarea raspunsurilor inflamatorii sistemice. Monocitoza poata sa apara si in infectii virale, ca de exemplu in mononucleoza infectioasa, oreion sau rujeola (pojar).
Constatarea monocitozei intr-o boala sau situatie acuta nu este nici sensibila, nici specifica pentru o anumita cauza. Cea mai adecvata evaluare diagnostica in situatia acuta este repetarea numaratorii de monocite odata ce raspunsul inflamator acut s-a rezolvat.\
Monocitoza persistenta (>3 luni)
- Infectii. Un grup divers de infectii subacute sau cronice au fost asociate cu monocitoza. Exemple sunt: tuberculoza, endocardita bacteriana subacuta, sifilis, bruceloza, malaria, leishmanioza viscerala (boala Kala Azar) si infectiile provocate de rickettsii (transmise prin intermediul muscaturii de capusa).
- Boli cronice autoimune. Exista 2 categorii majore: 1. Afectiuni granulomatoase, cum sunt sarcoidoza, histiocitoza cu celule Langerhans si boala inflamatorie intestinala (colita ulceroasa) si 2. Boli reumatologice sitemice, cum sunt poliartrita reumatoida, lupus eritematos sistemic (LES) si trombocitopenia mediata imun. Vasculita (poliarterita nodoasa) si miozita, lupusul si poliartrita reumatoida prezinta frecvent leucopenie (scaderea numarului de leucocite), inclusiv limfopenie (scaderea numarului de limfocite) si neutropenie (scaderea numarului de neutrofile).
- Medicamente. Anumite medicamente pot cauza monocitoza. Desi neutrofilia (cresterea numarului de neutrofile) este observata mai frecvent in cazul terapiei cu corticosteroizi, poate sa apara si monocitoza. Exemple de astfel de terapii si medicamente sunt: medicamente precum ziprasidona, factorul de stimulare a coloniilor de granulocite (G-CSF), imunoglobulina anti-timocit si radioterapia.
- Cancere. Exemple sunt: leucemia mielomonocitara cronica, leucemia mielomonocitara juvenila (varianta care apare la copii), leucemia monoblastica acuta, leucemia cu celule dendritice, boli mieloproliferative cronice si cancere la nivelul organelor solide, cum sunt cancerul de stomac, cancerul de san sau cancerul ovarian.
Simptome
Monocitoza in sine nu determina simptome. Totusi, pacientii pot avea semne si simptome specifice bolii care a cauzat cresterea numarului de monocite.
Diagnostic
Diagnosticul de monocitoza se face pe baza analizei hemoleucograma efectuate atunci cand o persoana are semne sau simptome ale unei infectii sau boli autoimune. Uneori, un numar crescut de monocite este descoperit intamplator atunci cand se face hemoleucograma in timpul unui control medical de rutina sau pentru evaluarea unei alte afectiuni.
Deoarece afectiunile care pot cauza monocitoza sunt extrem de variate, nu exista un singur test pentru evaluarea sa. Este important sa se diferentieze intre cauzele infectioase, reumatologice si maligne. Diagnosticul va necesita combinarea elementelor obtinute in urma examenului fizic si al istoricul medical cu rezultatele investigatiilor de imagistica, analizelor de laborator si diverselor proceduri de diagnostic.
- In functie de simptome si semne, se recomanda efectuarea unei radiografii toracice si a unor teste generale pentru infectii.
- Daca se ia in considerare existenta unui cancer, urmatoarele analize pot fi utile si diagnostice: examen citologic al frotiului de sange periferic, citometria in flux, biopsia maduvei osoase si biopsia ganglionilor limfatici. Un cancer de sange va necesita o abordare multidisciplinara in care medicul hematolog are un rol cheie in diagnostic.
- Daca se suspicioneaza o cauza reumatologica, analize de laborator cum sunt Ac anti nucleari (AAN) si factorul reumatoid ii pot permite medicului sa restranga diagnosticul diferential.
Tratament
Monocitoza in sine este doar un semn si nu necesita tratament. Tratamentul afectiunii de baza cauzatoare va determina rezolvarea cresterii numarului de monocite.
In general, tratamentul poate include urmatoarele:
- Tratamentul infectiilor virale se concentreaza de obicei pe managementul simptomelor.
- Antibioticele pot trata doar infectiile bacteriene, precum tuberculoza.
- Exista multe boli parazitare; vor fi necesare teste de laborator pentru a determina cauza exacta inainte de a putea stabili tratamentul.
- Managementul cancerelor de sange poate include: chimioterapie, radioterapie, transplant de celule stem si interventii chirurgicale.
Prognostic
Un numar mare de monocite este un semn al multor afectiuni care sunt tratate in moduri diferite. Odata ce se cunoaste cauza de baza, vei avea o idee mai buna despre modul in care afectiunea iti poate afecta viata de zi cu zi.
Preventie
Monocitoza este un semn al unei infectii sau al unei alte afectiuni. Ca urmare, cel mai bun mod de a preveni monocitoza este evitarea infectiilor, gestionarea oricaror boli curente si mentinerea unei stari de sanatate bune, astfel incat sa ai in mod natural un sistem imunitar functional.
Recomandarile generale pentru a avea o sanatate buna sunt:
- Mananca o dieta echilibrata, cu multe fructe si legume si limiteaza alimentele care provoaca inflamatii, cum ar fi carnea rosie, prajelile si carbohidratii rafinati
- Practica sport regulat
- Mentine o greutate sanatoasa
- Dormi suficient (7-8 ore de somn odihnitor)
- Nu fuma
- Consuma alcool cu moderatie
- Redu stresul
- Mergi regulat la controalele medicale
De asemenea, urmatorii pasi sunt foarte importanti pentru a preveni infectiile:
- Spala-te corect pe maini
- Ingrijeste-ti dantura
- Gateste adecvat alimentele
- Evita expunerea la persoanele bolnave; evita multimile de oameni
- Urmeaza schema de vaccinare recomandata pentru varsta ta
Ce intrebari ar trebui sa-i adresezi medicului?
A fi diagnosticat cu monocitoza este un prim semn ca ai putea avea o afectiune cronica importanta. Sau este posibil sa fi fost deja diagnosticat cu aceasta boala. In orice caz, este posibil sa ai nelamuriri si sa vrei sa ii pui intrebari medicului. Iata cateva intrebari care te pot ajuta in discutia cu medicul tau:
- Ce este monocitoza?
- De ce am monocitoza?
- Asta inseamna ca am o boala grava?
- Cum aflu ce mi-a cauzat monocitoza?
- Cat de curand voi afla ce este in neregula cu mine?
- Stiu ca am o afectiune care provoaca un numar mare de monocite. Un numar mare de monocite inseamna ca starea mea se inrautateste?
Surse de informatie:
www.msdmanuals.com
www.icliniq.com
www.medscape.com
www.my.clevelandclinic.org
www.ncbi.nlm.nih.gov
www.cancertherapyadvisor.com
www.healthline.com
Text: Dr. Ileana Andreescu, Senior Medical Editor